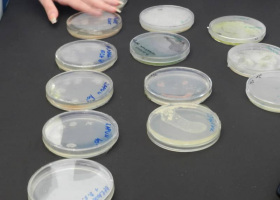
DSCN1595

- Upis
- O školi
-
-
- O ŠKOLI
- O International Schoolu
- Upravni odbor
- Akreditacija
- Misija i vizija
- Cambridge Global Perspectives škola
- Elite HONOURS CLASS
- Eko-škola
- Future-ready škola
- UCAS registrovani centar
- Pravilnici International Schoola
- Standardi kvaliteta
- Utisci i uspesi naših učenika
- Naši uspešni alumnisti širom sveta
- Family Support Hub
- Tri nivoa podrške za vaš uspeh
-
-
- Cambridge program
-
-
- CAMBRIDGE PRIMARY (5-11 godina)
- Sve o Primary programu
- Cambridge Primary program
- Cambridge Primary kurikulum
- Cambridge Primary testiranja i izveštaji
- Cambridge Primary predmeti
- Školarine za Cambridge Primary program
- Šta čini Primary program najboljim izborom za vaše dete?
- 10 razloga zašto da izaberete Cambridge Primary
- Zašto je važno gde dete započinje svoje školovanje?
- Jedan dan u životu naših osnovaca
- Fun and Study Hub
-
- CAMBRIDGE LOWER SECONDARY (11-14 godina)
- Cambridge LS program
- Cambridge LS kurikulum
- Cambridge LS predmeti
- Školarine za Cambridge LS
- Cambridge LS sertifikati i diploma
- Cambridge LS procene i testovi
- Cambridge LS Akademski kalendar
- 10 razloga da izaberete CLS
- Šta čini CLS sjajnim izborom za školovanje?
- Zašto da vaše dete od 6. razreda pređe u IS?
-
-
- Cambridge DL program
- Cambridge International Distance Learning
- Cambridge International DL programi i kvalifikacije
- Cambridge International DL procene znanja i ispiti
- Školarine za Cambridge International DL
- Cambridge International DL pravila i propisi
- DL platforma
- Individualni pristup u radu sa učenicima
- Fokus na lični razvoj učenika
- Za roditelje
- Obrazovanje za 21. vek
-
- Tehnologija u nastavi
- Vesti
- Erasmus +
- Savremena